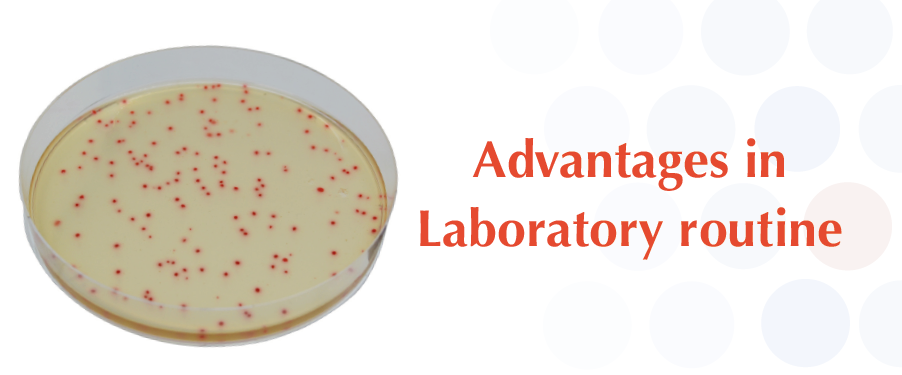

CHROMagar™ C.perfringens is the only culture media designed to detect and enumerate Clostridium perfringens in food and water samples.
Specific and selective, this medium detects Clostridium perfringens colonies by an intense orange colouration, the other microorganisms being blue, metallic blue or inhibited.
Performances: Specific medium for Clostridium perfringens while TSC medium detects sulfate-reducing bacteria, including non pathogens.
